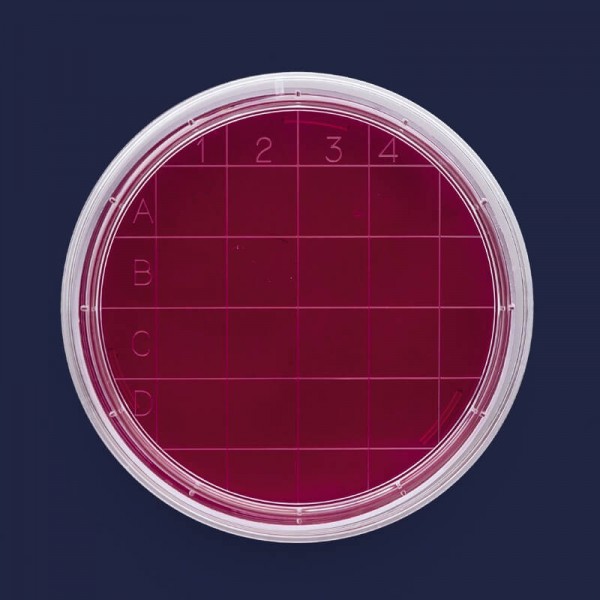

- Stokta yok
Petri Kutusu Rodak - 60 mm - Steril A (500 Adet)
Katalog No: 081.04.060
Marka: İsolab
- Bir değerlendirme yazın
İsolab 081.04.060 Petri Kutusu Rodak - 60 mm - Steril A (500 Adet)
 Güvenlik Politikası
Güvenlik Politikası
KVKK kapsamında kişisel bilgileriniz korumamız altında.
 Teslimat politikası
Teslimat politikası
Hızlı ve Güvenli Teslimat.
 İade politikası
İade politikası
15 gün iade garantisi.
İsolab 081.04.060 Petri Kutusu Rodak - 60 mm - Steril A (500 Adet)
Deri, çalışma tezgahları, ve diğer tüm yüzeylerdeki bakteriyolojik kontaminasyon testlerinde kullanılmak üzere son derece şeffaf polistirenden üretilirler.
Aynı zamanda koloni sayımıda yapılabilir.
İnsan eli değmeden tam otomatik makinalar ile üretilirler.
İdeal gövde formları otomatik dolum makinaları ile tam uyumlu çalışmayı garanti eder.
Kutu tabanında yer alan kabartma sayım indeksi kontamine partiküllerin cm2 alanda sayılmalarına olanak sağlar.
Aseptik petri kutuları bakterilerden arındırılmış 10.000 sınıfı steril alanlarda yüksek sterilite kontrolü altında üretilirler.
Steril petri kutuları bakterilerden arındırılmış 10.000 sınıfı steril alanlarda üretildikten sonra gama ışınları ile yeniden steril edilirler.
Steril petri kutuları “DNase, RNase, pirojen” içermediklerini belgeleyen test sertifikası ile teslim edilirler.